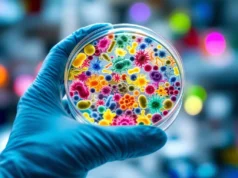
Découverte révolutionnaire : des microbes pour bloquer les allergies respiratoires

Fermeture de trois maisons médicales de garde dans les Yvelines
Ces maisons permettaient aux habitants de consulter un médecin en soirée, la nuit ou le week-end, sans avoir à se rendre aux urgences.
En raison d’un désaccord avec certains professionnels de santé, l’Agence régionale de santé (ARS) a décidé de fermer trois maisons médicales de garde dans les Yvelines. Ces structures, qui existaient depuis 2012, offraient une prise en charge en dehors des horaires classiques, notamment en soirée, la nuit, le week-end ou lors des jours fériés.
À l’origine, ces maisons bénéficiaient d’un régime de rémunération spécifique, plus favorable, car il était difficile de recruter des médecins dans ces structures. Cependant, l’ARS a choisi de revenir au système classique de paiement à partir du 1er janvier 2026. La décision a été annoncée dès 2022 dans le but d’harmoniser la rémunération des gardes avec celle des autres structures, afin que les médecins ne soient pas davantage rémunérés.
Ce calendrier laissait aux professionnels concernés près de quatre ans pour s’adapter. Mais ces derniers ont contesté cette évolution, ce qui a conduit à une grève dans les quatre maisons concernées. Selon l’ARS, ces structures n’ont pas voulu engager de discussions pour accompagner cette transition.
En conséquence, trois maisons situées à Mantes-la-Jolie, Montfort-l’Amaury, Montigny-le-Bretonneux et Les Mureaux ont fermé. L’ARS assure toutefois que la permanence des soins reste assurée dans le département. La régulation médicale du Centre 15 continue d’orienter les patients vers les solutions adaptées, comme le Service d’accès aux soins (SAS) ou les services d’urgence, qui fonctionnent sans interruption.
Après avoir rencontré les élus locaux, l’ARS indique son intention de maintenir un dispositif de maisons médicales de garde dans ces territoires. Les professionnels seront sollicités pour savoir s’ils souhaitent reprendre leur activité dans le cadre des conditions habituelles. Si aucun professionnel ne se porte volontaire, l’agence prévoit de lancer un nouvel appel à candidatures pour faire venir d’autres praticiens à même d’assurer cette mission.